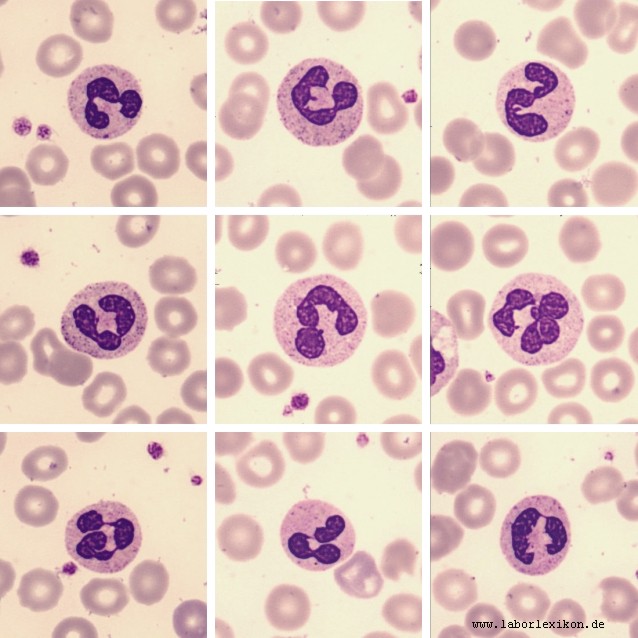

Nötrofil Granülosit
Sinonim: Neutrophil granulocyt, neutrophilic leukocyte, Neutrophiler, Granulocytus neutrophilicus, Neutrophile Granulozyten.
- Sitoplazmasındaki granüller, boyalara özel bir afinite (bağlanma eğilimi) göstermediği için “nötrofil” olarak adlandırılmıştır.. (bkz: Nötrofil ) (bkz: Granülosit).
- Lökositlerin ~60-65% ını oluşturur.
- Doğuştan kazanılmış bağışıklık sistemi hücresi olarak kabul edilir.
- Düz çekirdekli(genç) ve segment çekirdekli(olgun) hücre tipleri vardır.
- Yaşam süreleri çok kısa olan nötrofiller (ortalama olarak bir günden az) kemik iliğinde üretililer.
- Aktif fagositozlardır. Özellikle organizmayı mikroorganizmaların istilasından korurlar. Bazen küçük partikülleri de fagosite ederler. Bu yüzden büyük partikülleri fagosite eden makrofajlardan ayırmak için mikrofajlar da denir. (Psödopod, fagozom)
- Ölmüş nötrofiller, bakteriler, yarı yarıya sindirilmiş yapılar iltihaplı bölgede kıvamlı ve sarı renkte “cerahat-irin” birikmesine sebep olur.
- Nötrofil sayısının azalmasına nötropeni, artmasına ise nötrofili denir. Konjenital (kalıtsal bozukluk) olabileceği gibi çeşitli sebeplerden de ortaya çıkabilir. Kemoterapi gibi tedavilerin yan etkisi olarak da oluşabilir. Sistemik bir infeksiyon ya da yangı sonucu kandaki miktarları artar.
- Genel olarak viral enfeksiyonlarda nötrofil sayısı artmaz. (feline ınfectious peritonitis hariç)
- Kan damarı yoluyla organlara gidebilir. Fakat nötrofillerin yarısı, kan damarı duvarına yapışır.
- Kimyasallar ile hedef hücreyi kendilerine çekerler.
- İltihaplanma sırasında mediyatörlerin serbest kalmasını kontrol ederler.